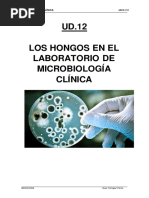

0% encontró este documento útil (0 votos)
164 vistas6 páginasCurso de Micología Médica
Este silabo presenta un curso de Micología que cubre los hongos que afectan al ser humano. El curso se enfoca en las características, clasificación, mecanismos de infección y propagación de los hongos, así como métodos de diagnóstico como cultivo e identificación. El curso desarrolla competencias para diagnosticar enfermedades fúngicas e incluye unidades sobre micosis superficiales, sistémicas y poco frecuentes, con énfasis en especies relevantes para el país. El curso utiliza métodos te
Cargado por
rosa eliza cornejo cornejoDerechos de autor
© © All Rights Reserved
Nos tomamos en serio los derechos de los contenidos. Si sospechas que se trata de tu contenido, reclámalo aquí.
Formatos disponibles
Descarga como PDF, TXT o lee en línea desde Scribd
0% encontró este documento útil (0 votos)
164 vistas6 páginasCurso de Micología Médica
Este silabo presenta un curso de Micología que cubre los hongos que afectan al ser humano. El curso se enfoca en las características, clasificación, mecanismos de infección y propagación de los hongos, así como métodos de diagnóstico como cultivo e identificación. El curso desarrolla competencias para diagnosticar enfermedades fúngicas e incluye unidades sobre micosis superficiales, sistémicas y poco frecuentes, con énfasis en especies relevantes para el país. El curso utiliza métodos te
Cargado por
rosa eliza cornejo cornejoDerechos de autor
© © All Rights Reserved
Nos tomamos en serio los derechos de los contenidos. Si sospechas que se trata de tu contenido, reclámalo aquí.
Formatos disponibles
Descarga como PDF, TXT o lee en línea desde Scribd